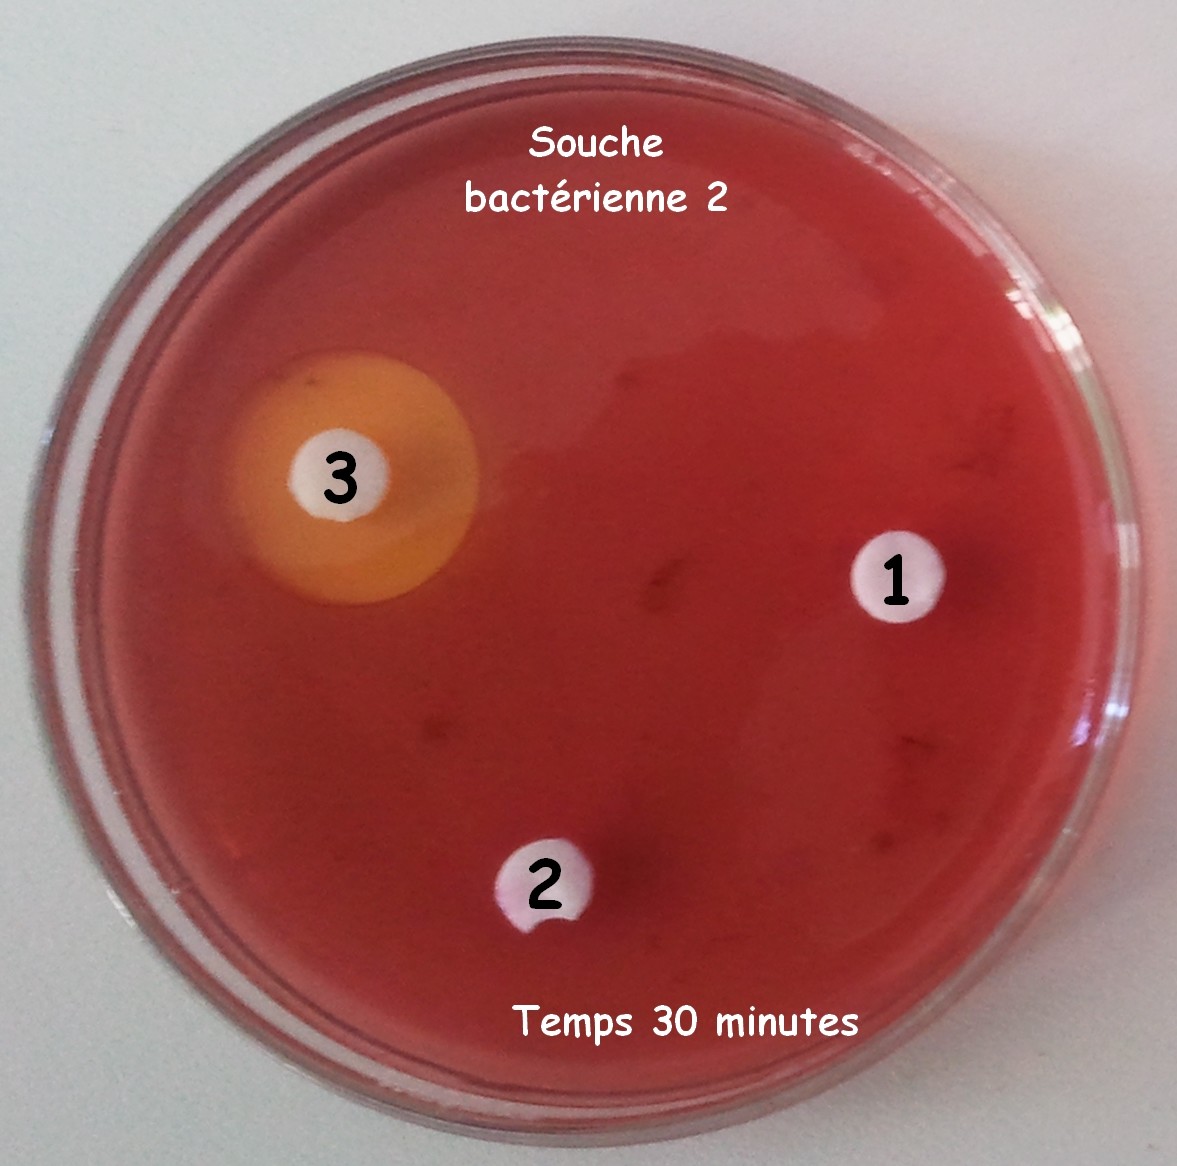
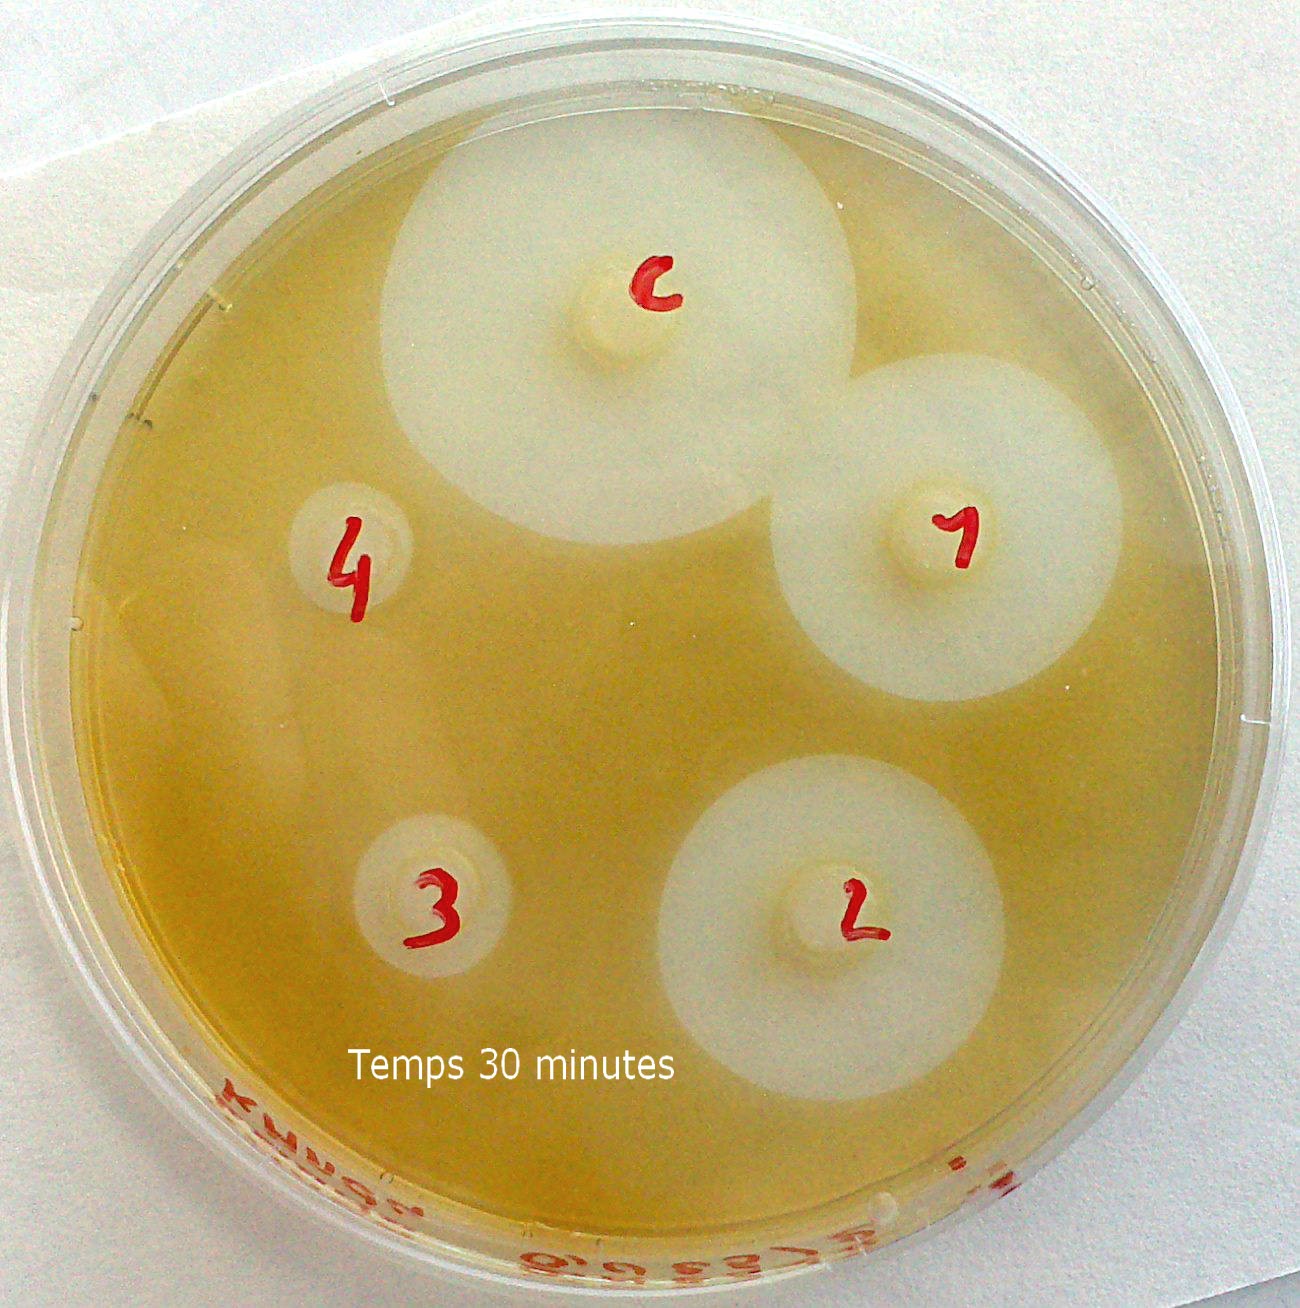

- 1ère S
- Terminale S
- Cycle 4
- travaux pratiques
- enseignant
- personnel de laboratoire
- laboratoire
préparation d'un antibiogramme de substitution
fiche préparateur pour l'antibiogramme de substitution

Préparation des boîtes de gélose
Préparation des boîtes de gélose : (quantité pour 24 boîtes de 10 cm de diamètre)
-mélanger 6 g d'agar-agar avec 400 mL d'eau.
-faire cuire sans cesser de mélanger.
-dès l'ébullition retirer du feu
-verser dans les boîtes de Pétri
Pastilles "d'antibiotiques"
Avec une perforatrice faire des pastilles dans du papier Canson, du Papier Wattman ou du coton démaquillant (préférer un papier épais pour avoir une diffusion plus régulière!) Plonger les pastilles dans les solutions
Préparation des produits de substitutions
Les colonies de bactéries seront simulées par des solutions colorées à étaler sur la gélose refroidie.
Ces solutions changent de couleur en fonction du pH.
| Colonies de bactéries et antibiotiques de substitution | Exemples de résultats |
| -"bactérie" : rouge de crésol (10 mL) -"antibiotiques" : Pastille 1 : HCl 1 mol/L Pastille 2 : HCl 3 mol/L Pastille 3 : NaOH 1 mol/L |  |
| -"bactérie" : rouge neutre (5 mL à 10g/L) -"antibiotiques" : Pastille 1 : HCl 1 mol/L Pastille 2 : HCl 3 mol/L Pastille 3 : NaOH 1 mol/L | |
| -"bactérie" : permanganate de potassium (0,0125 mol/L) -"antibiotiques" : sels de Mohr en concentration décroissante au 1/2 à chaque fois, la plus concentrée (pastille 0) étant à 0.5 mol/L | |
auteurs :
BLEJAN
contributeurs :
Virginie Boisnault, Emmanuel Level
Mots clés :
Information(s) pédagogique(s)
Niveau :
1ère S, Terminale S, Cycle 4
Type pédagogique :
travaux pratiques
Public visé :
enseignant, personnel de laboratoire
Contexte d'usage :
laboratoire
Référence aux programmes :
Expliquer les réactions qui permettent à l’organisme de se préserver des micro- organismes pathogènes.
Ressources associées
-

Choisir le bon antibiotique (Utilisation de produits de substitution)
- Cycle 4
- Terminale
- scénario, séquence
- enseignant
- élève
- classe
